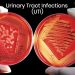
UTI

One of the most common eye problems that are usually seen after the 50s or 60s is the cataract. Statistics indicate that cataract is responsible for 50-80% of bilateral blindness in this country. Annually around 3.8 million people in India are diagnosed with cataract and around 9 million in India are today blind because of it. Many governmental, as well as non-governmental initiatives, have ensured that there is awareness and people seek medical help. Hence, there is an increase in the number of people availing timely cataract surgery, bringing down blindness incidence.
What, how and why of cataract
Most vision problems are correctable using glasses and treatments. However, a cataract is something that affects the lens of the eye by clouding it and can be treated only by surgery. If not treated, it will cause vision loss as well. The symptoms that you need to watch out for are blurred vision, difficulty in reading or glare. The exact cause of cataract is yet known, though age is one of the factors. The brighter part of this is that the cataract surgery is nowadays a highly evolved one and safe. In most cases, you don’t even have to get admitted. People can go in for the surgery in the morning and can be home by evening.
Join Now >
What is done in the surgery is that the cloudy lens in the eye is removed and an artificial lens is placed in its place so that normal vision is restored. Usually, protective dark glasses are provided after the surgery to be worn for a week to ten days. This keeps the eye protected any heat or dust or other pollutants as well as infections. There may be eye drops provided to be used for a week or so.
Ensure to approach only a proper, certified ophthalmologist or hospital for this. If the doctor decides on operating you, your medical records for other issues like diabetes or blood pressure etc. will also be checked. You will also be issued pre-operative instructions which need to be followed diligently. You may be asked not to eat or drink anything after midnight the previous day. You may have to be present a couple of hours before the surgery for preparation like sedation if required.
A minor irritation or pain may be felt and complications are usually almost nil. Follow the instructions and medications provided and also go for the postoperative check-ups as needed without fail. Visit your doctor, if you feel that you have any inflammation, or high irritation or a sense of too much pressure in your eyes.
Glaucoma
The estimated cases of glaucoma in India are around 12 million, which is said to be about one-fifth of the global numbers. It is the third major cause of blindness in India and a survey also noted that 90% of the cases were undiagnosed. In this disease, the optic nerve is damaged and people experience, progressive loss of vision, which unfortunately is also irreversible. There are many different types of glaucoma, however, it is said that heredity is a common cause.
Sometimes, there are no symptoms of glaucoma that is seen, and people are unaware of its progress. So, it is quite possible that by the time they seek medical help, the disease has progressed to an extent where nothing much can be done. However, in one form of glaucoma, hazy or blurred vision, pain in the eye or a headache, nausea, or appearance of rainbow colours around bright light may be seen. It is important to go for regular eye checkups, at least once in 6 months, even without any issues, and immediately if any issue is seen or felt. If caught early on, glaucoma too can be treated.
What, how and why of glaucoma
The ophthalmologist will decide on the course of treatment, depending on the type of glaucoma, the stage that it is at, the medical history, etc. At times, medication, and others, surgery (different types) may be advised. Follow the doctor’s guidelines strictly with respect to the medications to ensure that your vision is not affected. If advised surgery, pre and post surgery advice is usually issued by the doctor and needs to be followed strictly for proper healing and benefits. It is, again, not a very complicated process and very common, nowadays. Each case may be different, and the pre and post-operative instructions too will be dependent on the person and not common.